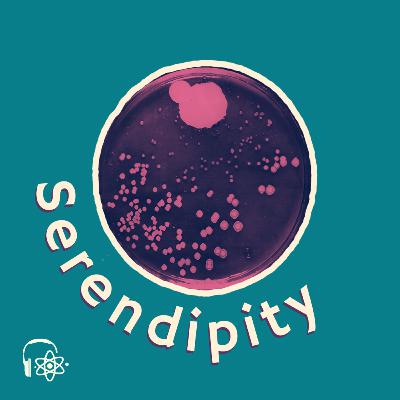

Essa Química Tem História
Subscribed: 1Played: 4
Subscribe
© PET Química UFPE
Description
Este podcast, oferecido pelos membros do PET QUÍMICA UFPE, contará com episódios cobrindo a história de varias descobertas e personalidades do mundo científico!
10 Episodes
Reverse
Comments